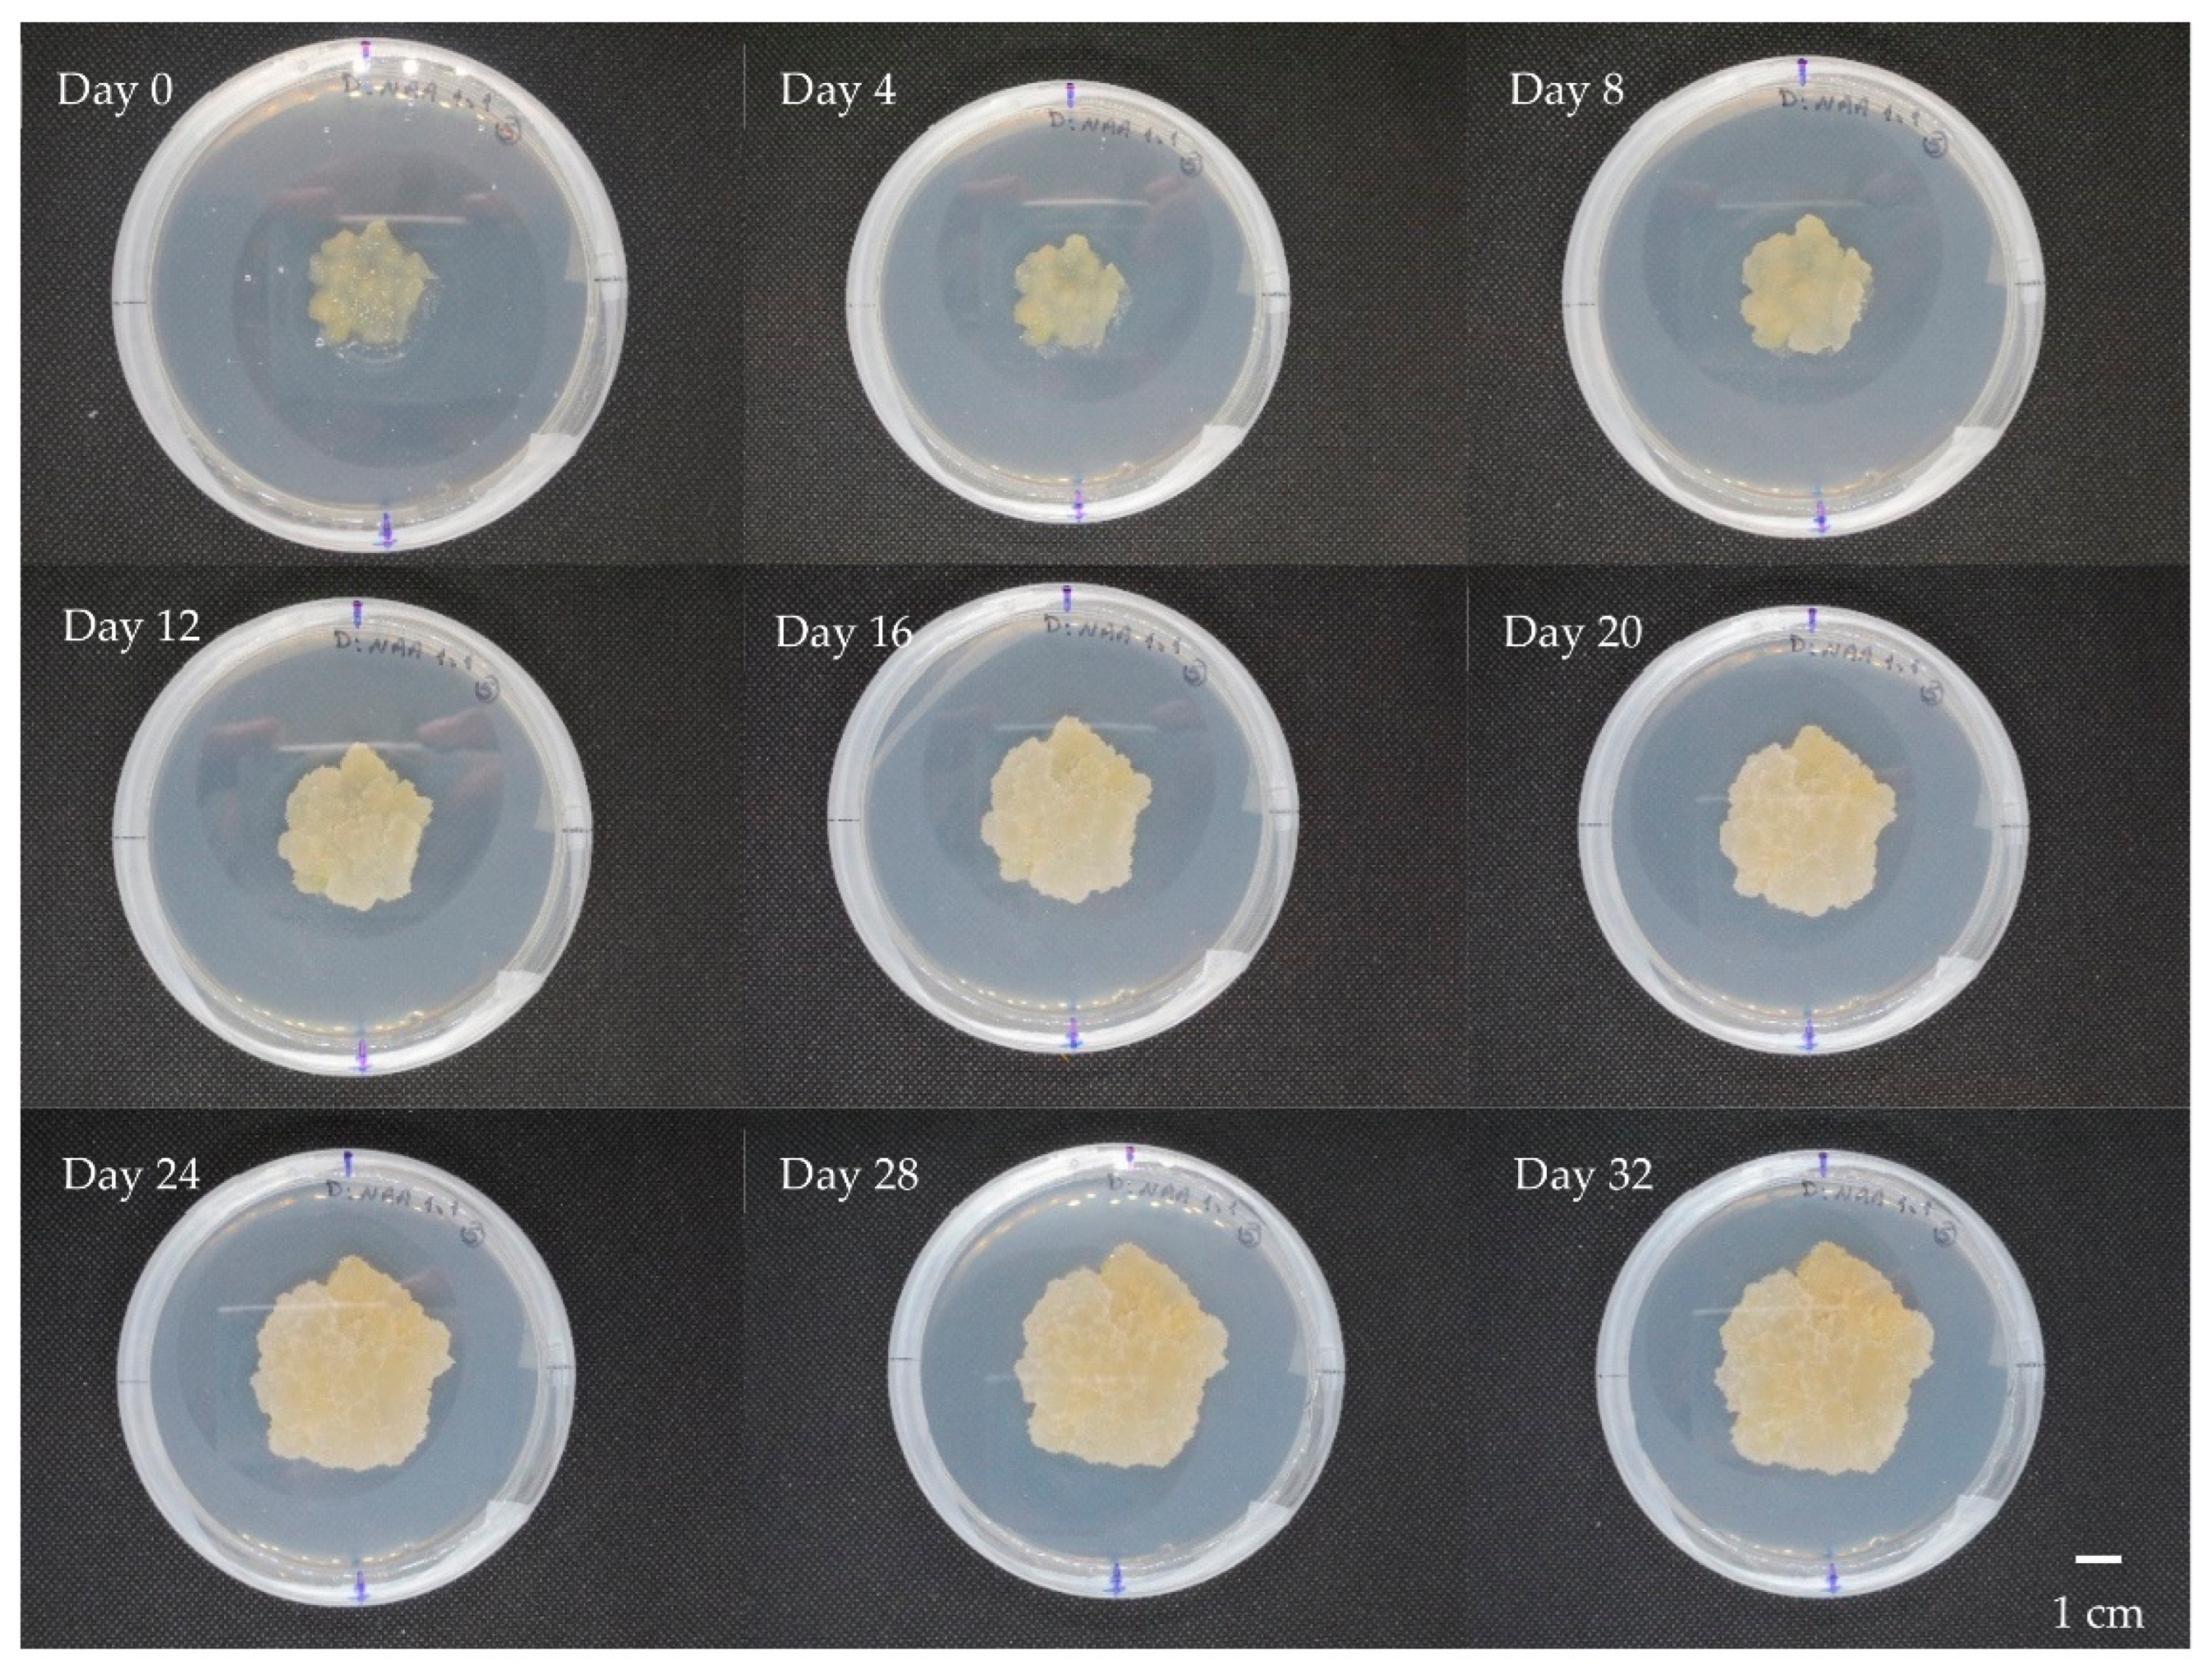
Horticulturae 08 00394 g003

Optimization of Callus and Cell Suspension Cultures of Lycium schweinfurthii for Improved Production of Phenolics, Flavonoids, and Antioxidant Activity
Abstract
:1. Introduction
2. Materials and Methods
2.1. Plant Material and Culture Conditions
2.2. Callus Induction and Multiplication
2.3. Cell Suspension Cultures
2.4. Cell Viability Test
2.5. Sample Preparation and Extraction
2.6. Total Phenolic Assay
2.7. Total Flavonoid Assay
2.8. Antioxidant Capacity
2.9. DPPH Antioxidant Capacity
2.10. ABTS Antioxidant Capacity
2.11. Recording Data and Statistical Analysis
3. Results and Discussion
3.1. Callus Induction and Multiplication
3.2. Cell Suspension Cultures
3.3. Estimation of Phenolics, Flavonoids, and Antioxidant Capacity
4. Conclusions
Supplementary Materials
Author Contributions
Funding
Institutional Review Board Statement
Informed Consent Statement
Data Availability Statement
Conflicts of Interest
References
- Yao, R.; Heinrich, M.; Weckerle, C.S. The genus Lycium as food and medicine: A botanical, ethnobotanical and historical review. J. Ethnopharmacol. 2018, 212, 50–66. [Google Scholar] [CrossRef] [PubMed] [Green Version]
- Konarska, A. Microstructural and histochemical characteristics of Lycium barbarum L. fruits used in folk herbal medicine and as functional food. Protoplasma 2018, 255, 1839–1854. [Google Scholar] [CrossRef] [PubMed] [Green Version]
- Wink, M. Modes of Action of Herbal Medicines and Plant Secondary Metabolites. Medicines 2015, 2, 251–286. [Google Scholar] [CrossRef] [PubMed]
- Abou Auda, M. An ethnobotanical uses of plants in the middle area, gaza strip, Palestine. —Free Online Library. Adv. Environ. Biol. 2011, 5, 3681–3687. [Google Scholar]
- Ewais, E.A.; Abd El-Maboud, M.M.; Elhaw, M.H.; Haggag, M.I. Phytochemical studies on Lycium schweinfurthii var. schweinfurthii (Solanaceae) and Isolation of five Flavonoids from leaves. J. Med. Plants Stud. 2016, 4, 288–300. [Google Scholar]
- Jamous, R.; Zaitoun, S.; Husein, A.; Qasem, I.; Ali-Shtayeh, M. Screening for Biological Activities of Medicinal Plants Used in Traditional Arabic Palestinian Herbal Medicine. Eur. J. Med. Plants 2015, 9, 1–13. [Google Scholar] [CrossRef]
- Baghdadi, H.H.; El-Sayed, S.H.; Salem, G.A.; Metwally, A.M. A comparative chemical study of Lycium species growing in Egypt. Alex. J. Pharm. Sci. 1988, 2, 73–76. [Google Scholar]
- Yao, X.; Peng, Y.; Xu, L.J.; Li, L.; Wu, Q.L.; Xiao, P.G. Phytochemical and biological studies of Lycium medicinal plants. Chem. Biodivers. 2011, 8, 976–1010. [Google Scholar] [CrossRef]
- Elbermawi, A.; Halim, A.F.; Mansour, E.S.S.; Ahmad, K.F.; Elsbaey, M.; Ashour, A.; Amen, Y.; El-Gamil, M.M.; Tomofumi, M.; Shimizu, K. Lycium schweinfurthii: New secondary metabolites and their cytotoxic activities. Nat. Prod. Res. 2021, 1–8. [Google Scholar] [CrossRef]
- Elbermawi, A.; Halim, A.F.; Mansour, E.S.S.; Ahmad, K.F.; Ashour, A.; Amen, Y.; Shimizu, K. A new glucoside with a potent α-glucosidase inhibitory activity from Lycium schweinfurthii. Nat. Prod. Res. 2021, 35, 976–983. [Google Scholar] [CrossRef]
- Farjaminezhad, R.; Zare, N.; Asghari-Zakaria, R.; Farjaminezhad, M. Establishment and optimization of cell growth in suspension culture of Papaver bracteatum: A biotechnology approach for thebaine production. Turkish J. Biol. 2013, 37, 689–697. [Google Scholar] [CrossRef]
- Zare, N.; Valizadeh, M.; Tohidfar, M.; Mohammadi, S.A.; Malboobi, M.A.; Habashi, A.A. Selection of regenerative genotypes from Iranian alfalfa cultivars. J. Food Agric. Environ. 2009, 7, 567–572. [Google Scholar]
- Zakaria, R.A.; Hour, M.H.; Zare, N. Callus production and regeneration of the medicinal plant Papaver orientale. Af. J. Biotechnol. 2011, 10, 11152–11156. [Google Scholar] [CrossRef]
- Singh, T.; Sharma, U.; Agrawal, V. Isolation and optimization of plumbagin production in root callus of Plumbago zeylanica L. augmented with chitosan and yeast extract. Ind. Crops Prod. 2020, 151, 112446. [Google Scholar] [CrossRef]
- Mathur, A.; Kumar Mathur, A.; Gangwar, A.; Yadav, S.; Verma, P.; Singh Sangwan, R. Anthocyanin production in a callus line of Panax sikkimensis Ban. In Vitro Cell. Dev. Biol.-Plant 2010, 46, 13–21. [Google Scholar] [CrossRef]
- Cushnie, T.P.T.; Lamb, A.J. Recent advances in understanding the antibacterial properties of flavonoids. Int. J. Antimicrob. Agents 2011, 38, 99–107. [Google Scholar] [CrossRef] [PubMed]
- Smetanska, I. Sustainable Production of Polyphenols and Antioxidants by Plant In Vitro Cultures. In Reference Series in Phytochemistry; Springer: Cham, Germany, 2018; pp. 225–269. [Google Scholar]
- Tattini, M.; Galardi, C.; Pinelli, P.; Massai, R.; Remorini, D.; Agati, G. Differential accumulation of flavonoids and hydroxycinnamates in leaves of Ligustrum vulgare under excess light and drought stress. N. Phytol. 2004, 163, 547–561. [Google Scholar] [CrossRef]
- Barceló, J.; Poschenrieder, C. Fast root growth responses, root exudates, and internal detoxification as clues to the mechanisms of aluminium toxicity and resistance: A review. Environ. Exp. Bot. 2002, 48, 75–92. [Google Scholar] [CrossRef]
- Ryan, K.G.; Swinny, E.E.; Markham, K.R.; Winefield, C. Flavonoid gene expression and UV photoprotection in transgenic and mutant Petunia leaves. Phytochemistry 2002, 59, 23–32. [Google Scholar] [CrossRef]
- Treutter, D. Significance of flavonoids in plant resistance: A review. Environ. Chem. Lett. 2006, 4, 147–157. [Google Scholar] [CrossRef]
- Banjarnahor, S.D.S.; Artanti, N. Antioxidant properties of flavonoids. Med. J. Indones. 2014, 23, 239–244. [Google Scholar] [CrossRef] [Green Version]
- Procházková, D.; Boušová, I.; Wilhelmová, N. Antioxidant and prooxidant properties of flavonoids. Fitoterapia 2011, 82, 513–523. [Google Scholar] [CrossRef] [PubMed]
- Cazarolli, L.; Zanatta, L.; Alberton, E.; Bonorino Figueiredo, M.S.; Folador, P.; Damazio, R.; Pizzolatti, M.; Barreto Silva, F.R. Flavonoids: Prospective Drug Candidates. Mini-Rev. Med. Chem. 2008, 8, 1429–1440. [Google Scholar] [CrossRef] [PubMed]
- Pietta, P.G. Flavonoids as antioxidants. J. Nat. Prod. 2000, 63, 1035–1042. [Google Scholar] [CrossRef]
- Maleki, S.J.; Crespo, J.F.; Cabanillas, B. Anti-inflammatory effects of flavonoids. Food Chem. 2019, 299, 125124. [Google Scholar] [CrossRef]
- Yamamoto, Y.; Gaynor, R.B. Therapeutic potential of inhibition of the NF-κB pathway in the treatment of inflammation and cancer. J. Clin. Investig. 2001, 107, 135–142. [Google Scholar] [CrossRef] [Green Version]
- Lani, R.; Hassandarvish, P.; Shu, M.H.; Phoon, W.H.; Chu, J.J.H.; Higgs, S.; Vanlandingham, D.; Abu Bakar, S.; Zandi, K. Antiviral activity of selected flavonoids against Chikungunya virus. Antivir. Res. 2016, 133, 50–61. [Google Scholar] [CrossRef]
- Manner, S.; Skogman, M.; Goeres, D.; Vuorela, P.; Fallarero, A. Systematic exploration of natural and synthetic flavonoids for the inhibition of Staphylococcus aureus biofilms. Int. J. Mol. Sci. 2013, 14, 19434–19451. [Google Scholar] [CrossRef] [Green Version]
- Peterson, J.J.; Dwyer, J.T.; Jacques, P.F.; McCullough, M.L. Associations between flavonoids and cardiovascular disease incidence or mortality in European and US populations. Nutr. Rev. 2012, 70, 491–508. [Google Scholar] [CrossRef] [Green Version]
- Rezende, B.A.; Pereira, A.; Cortes, S.; Lemos, V. Vascular effects of flavonoids. Curr. Med. Chem. 2016, 23, 87–102. [Google Scholar] [CrossRef]
- Gabr, A.M.M.; Mabrok, H.B.; Sytar, O.; Smetanska, I. Recent Advances Toward Development of Plant Cell Culture Process for Sustainable Production of Lignans and Their Health Benefits. In Exploring Plant Cells for the Production of Compounds of Interest; Springer: Cham, Germany, 2021; pp. 249–289. [Google Scholar]
- Haida, Z.; Syahida, A.; Ariff, S.M.; Maziah, M.; Hakiman, M. Factors Affecting Cell Biomass and Flavonoid Production of Ficus deltoidea var. kunstleri in Cell Suspension Culture System. Sci. Rep. 2019, 9, 9533. [Google Scholar] [CrossRef] [PubMed]
- Mamdouh, D.; Mahgoub, H.A.M.; Gabr, A.M.M.; Ewais, E.A.; Smetanska, I. Genetic stability, phenolic, flavonoid, ferulic acid contents, and antioxidant activity of micropropagated Lycium schweinfurthii plants. Plants 2021, 10, 2089. [Google Scholar] [CrossRef]
- Talukder, P.; Talapatra, S.; Ghoshal, N.; Sen Raychaudhuri, S. Antioxidant activity and high-performance liquid chromatographic analysis of phenolic compounds during in vitro callus culture of Plantago ovata Forsk. and effect of exogenous additives on accumulation of phenolic compounds. J. Sci. Food Agric. 2016, 96, 232–244. [Google Scholar] [CrossRef] [PubMed]
- Danova, K.; Erst, A.A.; Petruk, A.A.; Erst, A.S.; Krivenko, D.A.; Filinova, N.V.; Maltseva, S.Y.; Kulikovskiy, M.S.; Banaev, E.V.; Timiryazev, K.A. Optimization of Biomass Accumulation and Production of Phenolic Compounds in Callus Cultures of Rhodiola rosea L. Using Design of Experiments. Plants 2022, 11, 124. [Google Scholar] [CrossRef]
- Coskun, Y.; Duran, R.E.; Kilic, S. Striking effects of melatonin on secondary metabolites produced by callus culture of rosemary (Rosmarinus officinalis L.). Plant Cell Tissue Organ Cult. 2019, 138, 89–95. [Google Scholar] [CrossRef]
- Heydari, H.R.; Chamani, E.; Esmaielpour, B. Cell line selection through gamma irradiation combined with multi-walled carbon nanotubes elicitation enhanced phenolic compounds accumulation in Salvia nemorosa cell culture. Plant Cell Tissue Organ Cult. 2020, 142, 353–367. [Google Scholar] [CrossRef]
- Sae-Lee, N.; Kerdchoechuen, O.; Laohakunjit, N. Enhancement of Phenolics, Resveratrol and Antioxidant Activity by Nitrogen Enrichment in Cell Suspension Culture of Vitis vinifera. Molecules 2014, 19, 7901–7912. [Google Scholar] [CrossRef] [Green Version]
- Mendoza, D.; Cuaspud, O.; Arias, J.P.; Ruiz, O.; Arias, M. Effect of salicylic acid and methyl jasmonate in the production of phenolic compounds in plant cell suspension cultures of Thevetia peruviana. Biotechnol. Rep. 2018, 19, e00273. [Google Scholar] [CrossRef]
- Li, Y.P.; Tang, D.B.; Wang, X.Q.; Wang, M.; Zhang, Q.F.; Liu, Y.; Shen, B.Y.; Chen, J.G.; Yin, Z.P. Development of Origanum vulgare Cell Suspension Culture to Produce Polyphenols and the Stimulation Effect of Salicylic Acid Elicitation and Phenylalanine Feeding. Biotechnol. Bioprocess Eng. 2021, 26, 456–467. [Google Scholar] [CrossRef]
- Gai, Q.Y.; Jiao, J.; Wang, X.; Fu, Y.J.; Lu, Y.; Liu, J.; Wang, Z.Y.; Xu, X.J. Establishment of Cajanus cajan (Linn.) Millsp. cell suspension cultures as an effective in vitro platform for the production of pharmacologically active phenolic compounds. Ind. Crops Prod. 2020, 158, 112977. [Google Scholar] [CrossRef]
- Açıkgöz, M.A. Effects of sorbitol on the production of phenolic compounds and terpenoids in the cell suspension cultures of Ocimum basilicum L. Biologia 2021, 76, 395–409. [Google Scholar] [CrossRef]
- Murashige, T.; Skoog, F. A Revised Medium for Rapid Growth and Bio Assays with Tobacco Tissue Cultures. Physiol. Plant 1962, 15, 473–497. [Google Scholar] [CrossRef]
- CABRI Guidelines Viability Test with 2,3,5-Triphenyltetrazolium Chloride (TTC). Available online: http://www.cabri.org/guidelines/plant/404.html (accessed on 23 January 2022).
- Olalere, O.A.; Abdurahman, H.N.; Yunus, R.B.M.; Alara, O.R.; Ahmad, M.M.; Zaki, Y.H.; Abdlrhman, H.S.M. Parameter study, antioxidant activities, morphological and functional characteristics in microwave extraction of medicinal oleoresins from black and white pepper. J. Taibah Univ. Sci. 2018, 12, 730–737. [Google Scholar] [CrossRef] [Green Version]
- Gabr, A.M.M.; Mabrok, H.B.; Ghanem, K.Z.; Blaut, M.; Smetanska, I. Lignan accumulation in callus and Agrobacterium rhizogenes-mediated hairy root cultures of flax (Linum usitatissimum). Plant Cell Tissue Organ Cult. 2016, 126, 255–267. [Google Scholar] [CrossRef]
- Binte Mostafiz, S.; Wagiran, A. Efficient Callus Induction and Regeneration in Selected Indica Rice. Agronomy 2018, 8, 77. [Google Scholar] [CrossRef] [Green Version]
- Jan, R.; Khan, M.A.; Asaf, S.; Lee, I.J.; Kim, K.M. Modulation of sugar and nitrogen in callus induction media alter PAL pathway, SA and biomass accumulation in rice callus. Plant Cell Tissue Organ Cult. 2020, 143, 517–530. [Google Scholar] [CrossRef]
- Shirsat, R.; Kengar, A.; Rai, A. In-vitro Callogenesis and Screening of Antimicrobial Activity of Callus and Seed of Caesalpinia bonducella F.: A Threatened Medicinal Plant of Western Ghats. J. Pharm. Res. Int. 2021, 33, 76–89. [Google Scholar] [CrossRef]
- Rajila, M.; Arunprasath, A. In-Vitro Regeneration, Flowering & GC-MS Analysis in Callus of Lindernia madayiparense—An Endemic Plant to Madayipara, Kerala, India. Int. J. Conserv. Sci. 2020, 11, 783–790. [Google Scholar]
- Bagheri, F.; Tahvilian, R.; Karimi, N.; Chalabi, M.; Azami, M. Shikonin Production by Callus Culture of Onosma bulbotrichom as Active Pharmaceutical Ingredient. Iran. J. Pharm. Res. IJPR 2018, 17, 495. [Google Scholar]
- Mendoza, M.G.; Kaeppler, H.F. Auxin and sugar effects on callus induction and plant regeneration frequencies from mature embryos of wheat (Triticum aestivum L.). Vitr. Cell. Dev. Biol. Plant 2002, 38, 39–45. [Google Scholar] [CrossRef]
- Tao, H.; Shaolin, P.; Gaofeng, D.; Lanying, Z.; Gengguang, L. Plant regeneration from leaf-derived callus in Citrus grandis (pummelo): Effects of auxins in callus induction medium. Plant Cell Tissue Organ Cult. 2002, 69, 141–146. [Google Scholar] [CrossRef]
- Abdelmageed, A.H.A. Callus induction and plant regeneration of Michelia champaca (Magnoliaceae): A multipurpose tree. J. Med. Plants Res. 2012, 6, 3338–3344. [Google Scholar] [CrossRef] [Green Version]
- Isah, B.I.; Mustapha, Y.; Sani, L.A. Effect of types and concentrations of auxins on callus induction and primary somatic embryogenesis in low cyanide cassava cultivars (Manihot esculentum Cranz). Bayero J. Pure Appl. Sci. 2018, 11, 497–501. [Google Scholar] [CrossRef] [Green Version]
- Yasuda, T.; Fujii, Y.; Yamaguchi, T. Embryogenic Callus Induction from Coffea arabica Leaf Explants by Benzyladenine. Plant Cell Physiol. 1985, 26, 595–597. [Google Scholar] [CrossRef]
- Rahayu, S.; Roostika, I.; Bermawie, N. The effect of types and concentrations of auxins on callus induction of Centella asiatica. Nusant. Biosci. 2016, 8, 283–287. [Google Scholar] [CrossRef]
- AL-Hussaini, Z.; Yousif, S.A.; AL-Ajeely, S.A. Effect of Different Medium on Callus Induction and Regeneration in Potato Cultivars. Int. J. Curr. Microbiol. Appl. Sci. 2015, 4, 856–865. [Google Scholar]
- Verma, S.K.; Gantait, S.; Mukherjee, E.; Gurel, E. Enhanced somatic embryogenesis, plant regeneration and total phenolic content estimation in Lycium barbarum L.: A highly nutritive and medicinal plant. J. Crop Sci. Biotechnol. 2022, 1–9. [Google Scholar] [CrossRef]
- Zaman, M.A.K.; Azzeme, A.M.; Ramle, I.K.; Normanshah, N.; Ramli, S.N.; Shaharuddin, N.A.; Ahmad, S.; Abdullah, S.N.A. Induction, Multiplication, and Evaluation of Antioxidant Activity of Polyalthia bullata Callus, a Woody Medicinal Plant. Plants 2020, 9, 1772. [Google Scholar] [CrossRef]
- Solangi, S.K.; Qureshi, S.T.; Khan, I.A.; Raza, S. Establishment of in vitro callus in sugarcane (Saccharum officinarum L.) varieties influenced by different auxins. Afr. J. Biotechnol. 2016, 15, 1541–1550. [Google Scholar] [CrossRef]
- Taimori, N.; Kahrizi, D.; Abdossi, V.; Papzan, A.H. Cell dedifferentiation, callus induction and somatic embryogenesis in Crataegus spp. Cell. Mol. Biol. 2016, 62, 100–107. [Google Scholar]
- Osman, N.I.; Jaafar Sidik, N.; Awal, A. Effects of variations in culture media and hormonal treatments upon callus induction potential in endosperm explant of Barringtonia racemosa L. Asian Pac. J. Trop. Biomed. 2016, 6, 143–147. [Google Scholar] [CrossRef] [Green Version]
- Adil, M.; Ren, X.; Kang, D.I.; Thi, L.T.; Jeong, B.R. Effect of explant type and plant growth regulators on callus induction, growth and secondary metabolites production in Cnidium officinale Makino. Mol. Biol. Rep. 2018, 45, 1919–1927. [Google Scholar] [CrossRef] [PubMed]
- Keshvari, T.; Najaphy, A.; Kahrizi, D.; Zebarjadi, A. Callus induction and somatic embryogenesis in Stevia rebaudiana Bertoni as a medicinal plant. Cell. Mol. Biol. 2018, 64, 46–49. [Google Scholar] [CrossRef] [PubMed]
- Karakas, F.P. Efficient plant regeneration and callus induction from nodal and hypocotyl explants of goji berry (Lycium barbarum L.) and comparison of phenolic profiles in calli formed under different combinations of plant growth regulators. Plant Physiol. Biochem. 2020, 146, 384–391. [Google Scholar] [CrossRef]
- Golkar, P.; Moradi, M.; Garousi, G.A. Elicitation of Stevia Glycosides Using Salicylic Acid and Silver Nanoparticles Under Callus Culture. Sugar Tech 2019, 21, 569–577. [Google Scholar] [CrossRef]
- Ali, M.; Abbasi, B.H.; Ali, G.S. Elicitation of antioxidant secondary metabolites with jasmonates and gibberellic acid in cell suspension cultures of Artemisia absinthium L. Plant Cell Tissue Organ Cult. 2015, 120, 1099–1106. [Google Scholar] [CrossRef]
- Sánchez-Ramos, M.; Alvarez, L.; Romero-Estrada, A.; Bernabé-Antonio, A.; Marquina-Bahena, S.; Cruz-Sosa, F. Establishment of a Cell Suspension Culture of Ageratina pichinchensis (Kunth) for the Improved Production of Anti-Inflammatory Compounds. Plants 2020, 9, 1398. [Google Scholar] [CrossRef]
- Deepthi, S.; Satheeshkumar, K. Enhanced camptothecin production induced by elicitors in the cell suspension cultures of Ophiorrhiza mungos Linn. Plant Cell Tissue Organ Cult. 2016, 124, 483–493. [Google Scholar] [CrossRef]
- Sivanandhan, G.; Selvaraj, N.; Ganapathi, A.; Manickavasagam, M. Enhanced Biosynthesis of Withanolides by Elicitation and Precursor Feeding in Cell Suspension Culture of Withania somnifera (L.) Dunal in Shake-Flask Culture and Bioreactor. PLoS ONE 2014, 9, e104005. [Google Scholar] [CrossRef] [Green Version]
- Lian, M.-L.; Chakrabarty, D.; Paek, K.-Y. Effect of plant growth regulators and medium composition on cell growth and saponin production during cell-suspension culture of mountain ginseng (Panax ginseng C. A. mayer). J. Plant Biol. 2002, 45, 201–206. [Google Scholar] [CrossRef]
- Silveira, V.; Floh, E.I.S.; Handro, W.; Guerra, M.P. Effect of plant growth regulators on the cellular growth and levels of intracellular protein, starch and polyamines in embryogenic suspension cultures of Pinus taeda. Plant Cell Tissue Organ Cult. 2004, 76, 53–60. [Google Scholar] [CrossRef]
- Tan, S.H.; Musa, R.; Ariff, A.; Maziah, M. Effect of plant growth regulators on callus, cell suspension and cell line selection for flavonoid production from pegaga (Centella asiatica L. urban). Am. J. Biochem. Biotechnol. 2010, 6, 284–299. [Google Scholar] [CrossRef] [Green Version]
- Trong, T.T.; Truong, D.-H.; Nguyen, H.C.; Tran, D.-T.; Thi, H.-T.N.; Dang, G.D.; Huu, H.N. Biomass accumulation of Panax vietnamensis in cell suspension cultures varies with addition of plant growth regulators and organic additives. Asian Pac. J. Trop. Med. 2017, 10, 907–915. [Google Scholar] [CrossRef] [PubMed]
- Arya, S.S.; Rookes, J.E.; Cahill, D.M.; Lenka, S.K. Next-generation metabolic engineering approaches towards development of plant cell suspension cultures as specialized metabolite producing biofactories. Biotechnol. Adv. 2020, 45, 107635. [Google Scholar] [CrossRef] [PubMed]
- Ali, M.; Abbasi, B.H. Ihsan-ul-haq Production of commercially important secondary metabolites and antioxidant activity in cell suspension cultures of Artemisia absinthium L. Ind. Crops Prod. 2013, 49, 400–406. [Google Scholar] [CrossRef]
- Khanpour-Ardestani, N.; Sharifi, M.; Behmanesh, M. Establishment of callus and cell suspension culture of Scrophularia striata Boiss.: An in vitro approach for acteoside production. Cytotechnology 2015, 67, 475–485. [Google Scholar] [CrossRef] [Green Version]
- Mishra, M.R.; Srivastava, R.K.; Akhtar, N. Enhanced Alkaloid Production from Cell Culture System of Catharanthus roseus in Combined Effect of Nutrient Salts, Sucrose and Plant Growth Regulators. J. Biotechnol. Biomed. Sci. 2018, 1, 14–34. [Google Scholar] [CrossRef] [Green Version]
- Ochoa-Villarreal, M.; Howat, S.; Hong, S.M.; Jang, M.O.; Jin, Y.W.; Lee, E.K.; Loake, G.J. Plant cell culture strategies for the production of natural products. BMB Rep. 2016, 49, 149. [Google Scholar] [CrossRef]
- Robles-Martínez, M.; Barba-De la Rosa, A.P.; Guéraud, F.; Negre-Salvayre, A.; Rossignol, M.; Santos-Díaz, M.D.S. Establishment of callus and cell suspensions of wild and domesticated Opuntia species: Study on their potential as a source of metabolite production. Plant Cell Tissue Organ Cult. 2015, 124, 181–189. [Google Scholar] [CrossRef]
- Ali, A.M.A.; El-Nour, M.E.A.M.; Yagi, S.M. Total phenolic and flavonoid contents and antioxidant activity of ginger (Zingiber officinale Rosc.) rhizome, callus and callus treated with some elicitors. J. Genet. Eng. Biotechnol. 2018, 16, 677–682. [Google Scholar] [CrossRef]
- Kumari, A.; Naidoo, D.; Baskaran, P.; Doležal, K.; Nisler, J.; Van Staden, J. Phenolic and flavonoid production and antimicrobial activity of Gymnosporia buxifolia (L.) Szyszyl cell cultures. Plant Growth Regul. 2018, 86, 333–338. [Google Scholar] [CrossRef]
- Mendoza, D.; Arias, J.P.; Cuaspud, O.; Arias, M. Phytochemical Screening of Callus and Cell Suspensions Cultures of Thevetia peruviana. Braz. Arch. Biol. Technol. 2020, 63, 2020. [Google Scholar] [CrossRef]
- Bong, F.J.; Yeou Chear, N.J.; Ramanathan, S.; Mohana-Kumaran, N.; Subramaniam, S.; Chew, B.L. The development of callus and cell suspension cultures of Sabah Snake Grass (Clinacanthus nutans) for the production of flavonoids and phenolics. Biocatal. Agric. Biotechnol. 2021, 33, 101977. [Google Scholar] [CrossRef]
- Shah, P.; Modi, H.A. Comparative Study of DPPH, ABTS and FRAP Assays for Determination of Antioxidant Activity. Int. J. Res. Appl. Sci. Eng. Technol. 2015, 3, 636–641. [Google Scholar]
- Martysiak-Żurowska, D.; Wenta, W. A comparison of ABTS and DPPH methods for assessing the total antioxidant capacity of human milk. Acta Sci. Pol. Technol. Aliment. 2012, 11, 83–89. [Google Scholar]
- Floegel, A.; Kim, D.O.; Chung, S.J.; Koo, S.I.; Chun, O.K. Comparison of ABTS/DPPH assays to measure antioxidant capacity in popular antioxidant-rich US foods. J. Food Compos. Anal. 2011, 24, 1043–1048. [Google Scholar] [CrossRef]

| PGR | Concentration (mg L−1) | ||||||||||||||||||
|---|---|---|---|---|---|---|---|---|---|---|---|---|---|---|---|---|---|---|---|
| 2,4-D | - | 0.5 | 1 | 2 | - | - | - | - | - | - | 0.5 | 1 | 2 | - | - | - | 0.5 | 1 | 2 |
| NAA | - | - | - | - | 0.5 | 1 | 2 | - | - | - | - | - | - | 0.5 | 1 | 2 | 0.5 | 1 | 2 |
| BA | - | - | - | - | - | - | - | 0.5 | 1 | 2 | 1 | 1 | 1 | 1 | 1 | 1 | - | - | - |
| Medium | Fresh Weight (g), Mean ± SE | ||||||||
|---|---|---|---|---|---|---|---|---|---|
| Day 0 | Day 4 | Day 8 | Day 12 | Day 16 | Day 20 | Day 24 | Day 28 | Day 32 | |
| N1 | 1.00 ± 0.00 a | 1.41 ± 0.03 a | 1.40 ± 0.04 a | 2.39 ± 0.08 a | 2.88 ± 0.19 a | 3.05 ± 0.39 a | 3.29 ± 0.08 bc | 3.40 ± 0.28 bc | 4.93 ± 0.34 a |
| N2 | 1.00 ± 0.00 a | 1.33 ± 0.05 a | 1.57 ± 0.07 a | 1.79 ± 0.04 b | 1.79 ± 0.08 bc | 2.38 ± 0.07 b | 3.27 ± 0.22 ac | 4.47 ± 0.52 a | 4.9 ± 0.21 a |
| D1 | 1.00 ± 0.00 a | 1.28 ± 0.06 a | 1.52 ± 0.05 a | 1.62 ± 0.03 bc | 1.90 ± 0.04 b | 2.06 ± 0.22 bc | 3.47 ± 0.43 ac | 3.89 ± 0.48 ab | 5.42 ± 0.55 a |
| D2 | 1.00 ± 0.00 a | 1.17 ± 0.04 a | 1.39 ± 0.05 a | 1.80 ± 0.05 b | 1.91 ± 0.14 b | 1.93 ± 0.09 bc | 2.19 ± 0.13 bc | 2.70 ± 0.17 c | 3.97 ± 0.53 a |
| DN0.5 | 1.00 ± 0.00 a | 1.26 ± 0.05 a | 1.32 ± 0.04 a | 1.36 ± 0.10 c | 1.41 ± 0.01 c | 1.41 ± 0.21 c | 2.47 ± 0.16 bc | 3.93 ± 0.30 ab | 4.45 ± 0.34 a |
| DN1 | 1.00 ± 0.00 a | 1.22 ± 0.05 a | 1.52 ± 0.10 a | 1.74 ± 0.18 bc | 2.00 ± 0.12 b | 2.24 ± 0.12 bc | 4.24 ± 0.25 a | 4.85 ± 0.30 a | 5.20 ± 0.62 a |
| Sucrose Concentration (g L−1) | Absorbance at 500 nm (Mean ± SE) | Viability Degree |
|---|---|---|
| 5 | 0.136 ± 0.010 b | Low viability |
| 10 | 0.308 ± 0.029 ab | Viable |
| 15 | 0.340 ± 0.030 a | Viable |
| 20 | 0.398 ± 0.086 a | Viable |
| 25 | 0.330 ± 0.027 a | Viable |
| 30 | 0.488 ± 0.043 a | Highest viability |
| Media | Total Phenolics (µg g−1) | Total Flavonoids (µg g−1) | DPPH (%) | ABTS+ (%) |
|---|---|---|---|---|
| N1 | 64.87 ± 3.61 a | 12.90 ± 1.20 b | 52.44 ± 2.09 ab | 50.79±3.00a |
| N2 | 78.97 ± 10.12 a | 24.43 ± 4.24 a | 68.19 ± 10.65 a | 49.74±3.81a |
| D1 | 65.37 ± 12.48 a | 10.10 ± 0.42 b | 17.05 ± 4.03 b | 56.84±5.95a |
| D2 | 71.10 ± 17.64 a | 10.49 ± 0.99 b | 22.21 ± 5.19 ab | 61.65±7.28a |
| DN0.5 | 39.63 ± 3.44 a | 9.10 ± 0.36 b | 7.18 ± 1.45 b | 39.73±2.57a |
| DN1 | 63.56 ± 6.90 a | 10.61 ± 1.02 b | 39.12 ± 10.18 ab | 58.73±6.22a |
| Sucrose Concentration (g L−1) | Total Phenolics (µg g−1) | Total Flavonoids (µg g−1) | DPPH (%) | ABTS+ (%) |
|---|---|---|---|---|
| 5 | 78.59 ± 5.55 a | 13.71 ± 1.20 b | 33.19 ± 3.21 b | 27.43 ± 1.96 b |
| 10 | 44.64 ± 10.86 b | 9.56 ± 1.13 bc | 24.89 ± 3.17 bc | 23.32 ± 3.26 b |
| 15 | 22.19 ± 5.47 b | 9.47 ± 1.45 bc | 16.80 ± 0.67 c | 18.64 ± 1.93 b |
| 20 | 32.92 ± 2.83 b | 9.82 ± 0.52 bc | 32.53 ± 0.77 b | 21.65 ± 2.73 b |
| 25 | 33.70 ± 3.58 b | 8.36 ± 0.53 c | 32.40 ± 2.09 b | 29.85 ± 1.77 b |
| 30 | 84.27 ± 5.46 a | 19.14 ± 1.42 a | 49.46 ± 3.58 a | 56.29 ± 6.03 a |
Publisher’s Note: MDPI stays neutral with regard to jurisdictional claims in published maps and institutional affiliations. |
© 2022 by the authors. Licensee MDPI, Basel, Switzerland. This article is an open access article distributed under the terms and conditions of the Creative Commons Attribution (CC BY) license (https://creativecommons.org/licenses/by/4.0/).
Share and Cite
Mamdouh, D.; Smetanska, I. Optimization of Callus and Cell Suspension Cultures of Lycium schweinfurthii for Improved Production of Phenolics, Flavonoids, and Antioxidant Activity. Horticulturae 2022, 8, 394. https://doi.org/10.3390/horticulturae8050394
Mamdouh D, Smetanska I. Optimization of Callus and Cell Suspension Cultures of Lycium schweinfurthii for Improved Production of Phenolics, Flavonoids, and Antioxidant Activity. Horticulturae. 2022; 8(5):394. https://doi.org/10.3390/horticulturae8050394
Chicago/Turabian StyleMamdouh, Diaa, and Iryna Smetanska. 2022. "Optimization of Callus and Cell Suspension Cultures of Lycium schweinfurthii for Improved Production of Phenolics, Flavonoids, and Antioxidant Activity" Horticulturae 8, no. 5: 394. https://doi.org/10.3390/horticulturae8050394
APA StyleMamdouh, D., & Smetanska, I. (2022). Optimization of Callus and Cell Suspension Cultures of Lycium schweinfurthii for Improved Production of Phenolics, Flavonoids, and Antioxidant Activity. Horticulturae, 8(5), 394. https://doi.org/10.3390/horticulturae8050394

